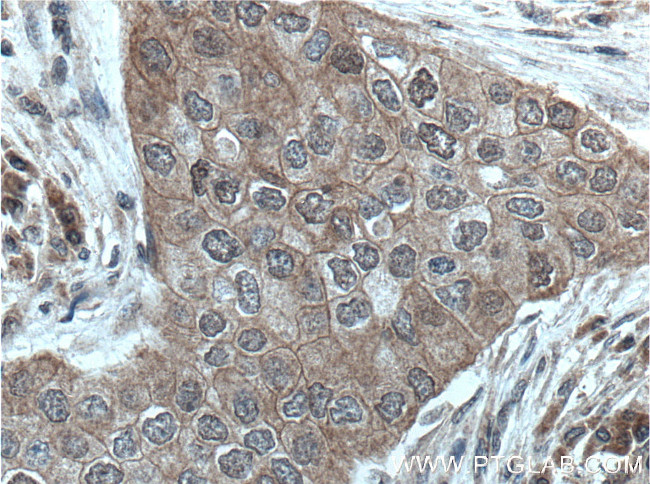
BAG6 Antibody in Immunohistochemistry (Paraffin) (IHC (P))
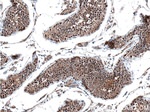
BAG6 Antibody in Immunohistochemistry (Paraffin) (IHC (P))

Search
Proteintech
BAG6 Monoclonal Antibody (1B8D3)
{{$productOrderCtrl.translations['antibody.pdp.commerceCard.promotion.promotions']}}
{{$productOrderCtrl.translations['antibody.pdp.commerceCard.promotion.viewpromo']}}
{{$productOrderCtrl.translations['antibody.pdp.commerceCard.promotion.promocode']}}: {{promo.promoCode}} {{promo.promoTitle}} {{promo.promoDescription}}. {{$productOrderCtrl.translations['antibody.pdp.commerceCard.promotion.learnmore']}}
产品信息
66661-1-IG
种属反应
宿主/亚型
分类
类型
克隆号
抗原
偶联物
形式
浓度
规格
纯化类型
保存液
内含物
保存条件
运输条件
靶标信息
This gene was first characterized as part of a cluster of genes located within the human major histocompatibility complex class III region. This gene encodes a nuclear protein that is cleaved by caspase 3 and is implicated in the control of apoptosis. In addition, the protein forms a complex with E1A binding protein p300 and is required for the acetylation of p53 in response to DNA damage. Multiple transcript variants encoding different isoforms have been found for this gene.
仅用于科研。不用于诊断过程。未经明确授权不得转售。
生物信息学
蛋白别名: BAG 6; BAG family molecular chaperone regulator 6; BAG-6; BAT 3; BCL2 associated athanogene 6; BCL2-associated athanogene 6; DAQB-195H10.3; HLA-B associated transcript 3; HLA-B-associated transcript 3; HLA-B-associated transcript 3 (BAT3); Large proline-rich protein BAG6; large proline-rich protein BAT3; Protein G3; Protein Scythe; scythe; unnamed protein product
基因别名: 2410045D21Rik; AA408914; BAG-6; BAG6; BAT3; D17H6S52E; D6S52E; G3; Scythe
UniProt ID: (Human) P46379, (Rat) Q6MG49, (Mouse) Q9Z1R2
Entrez Gene ID: (Human) 7917, (Rat) 94342, (Mouse) 224727